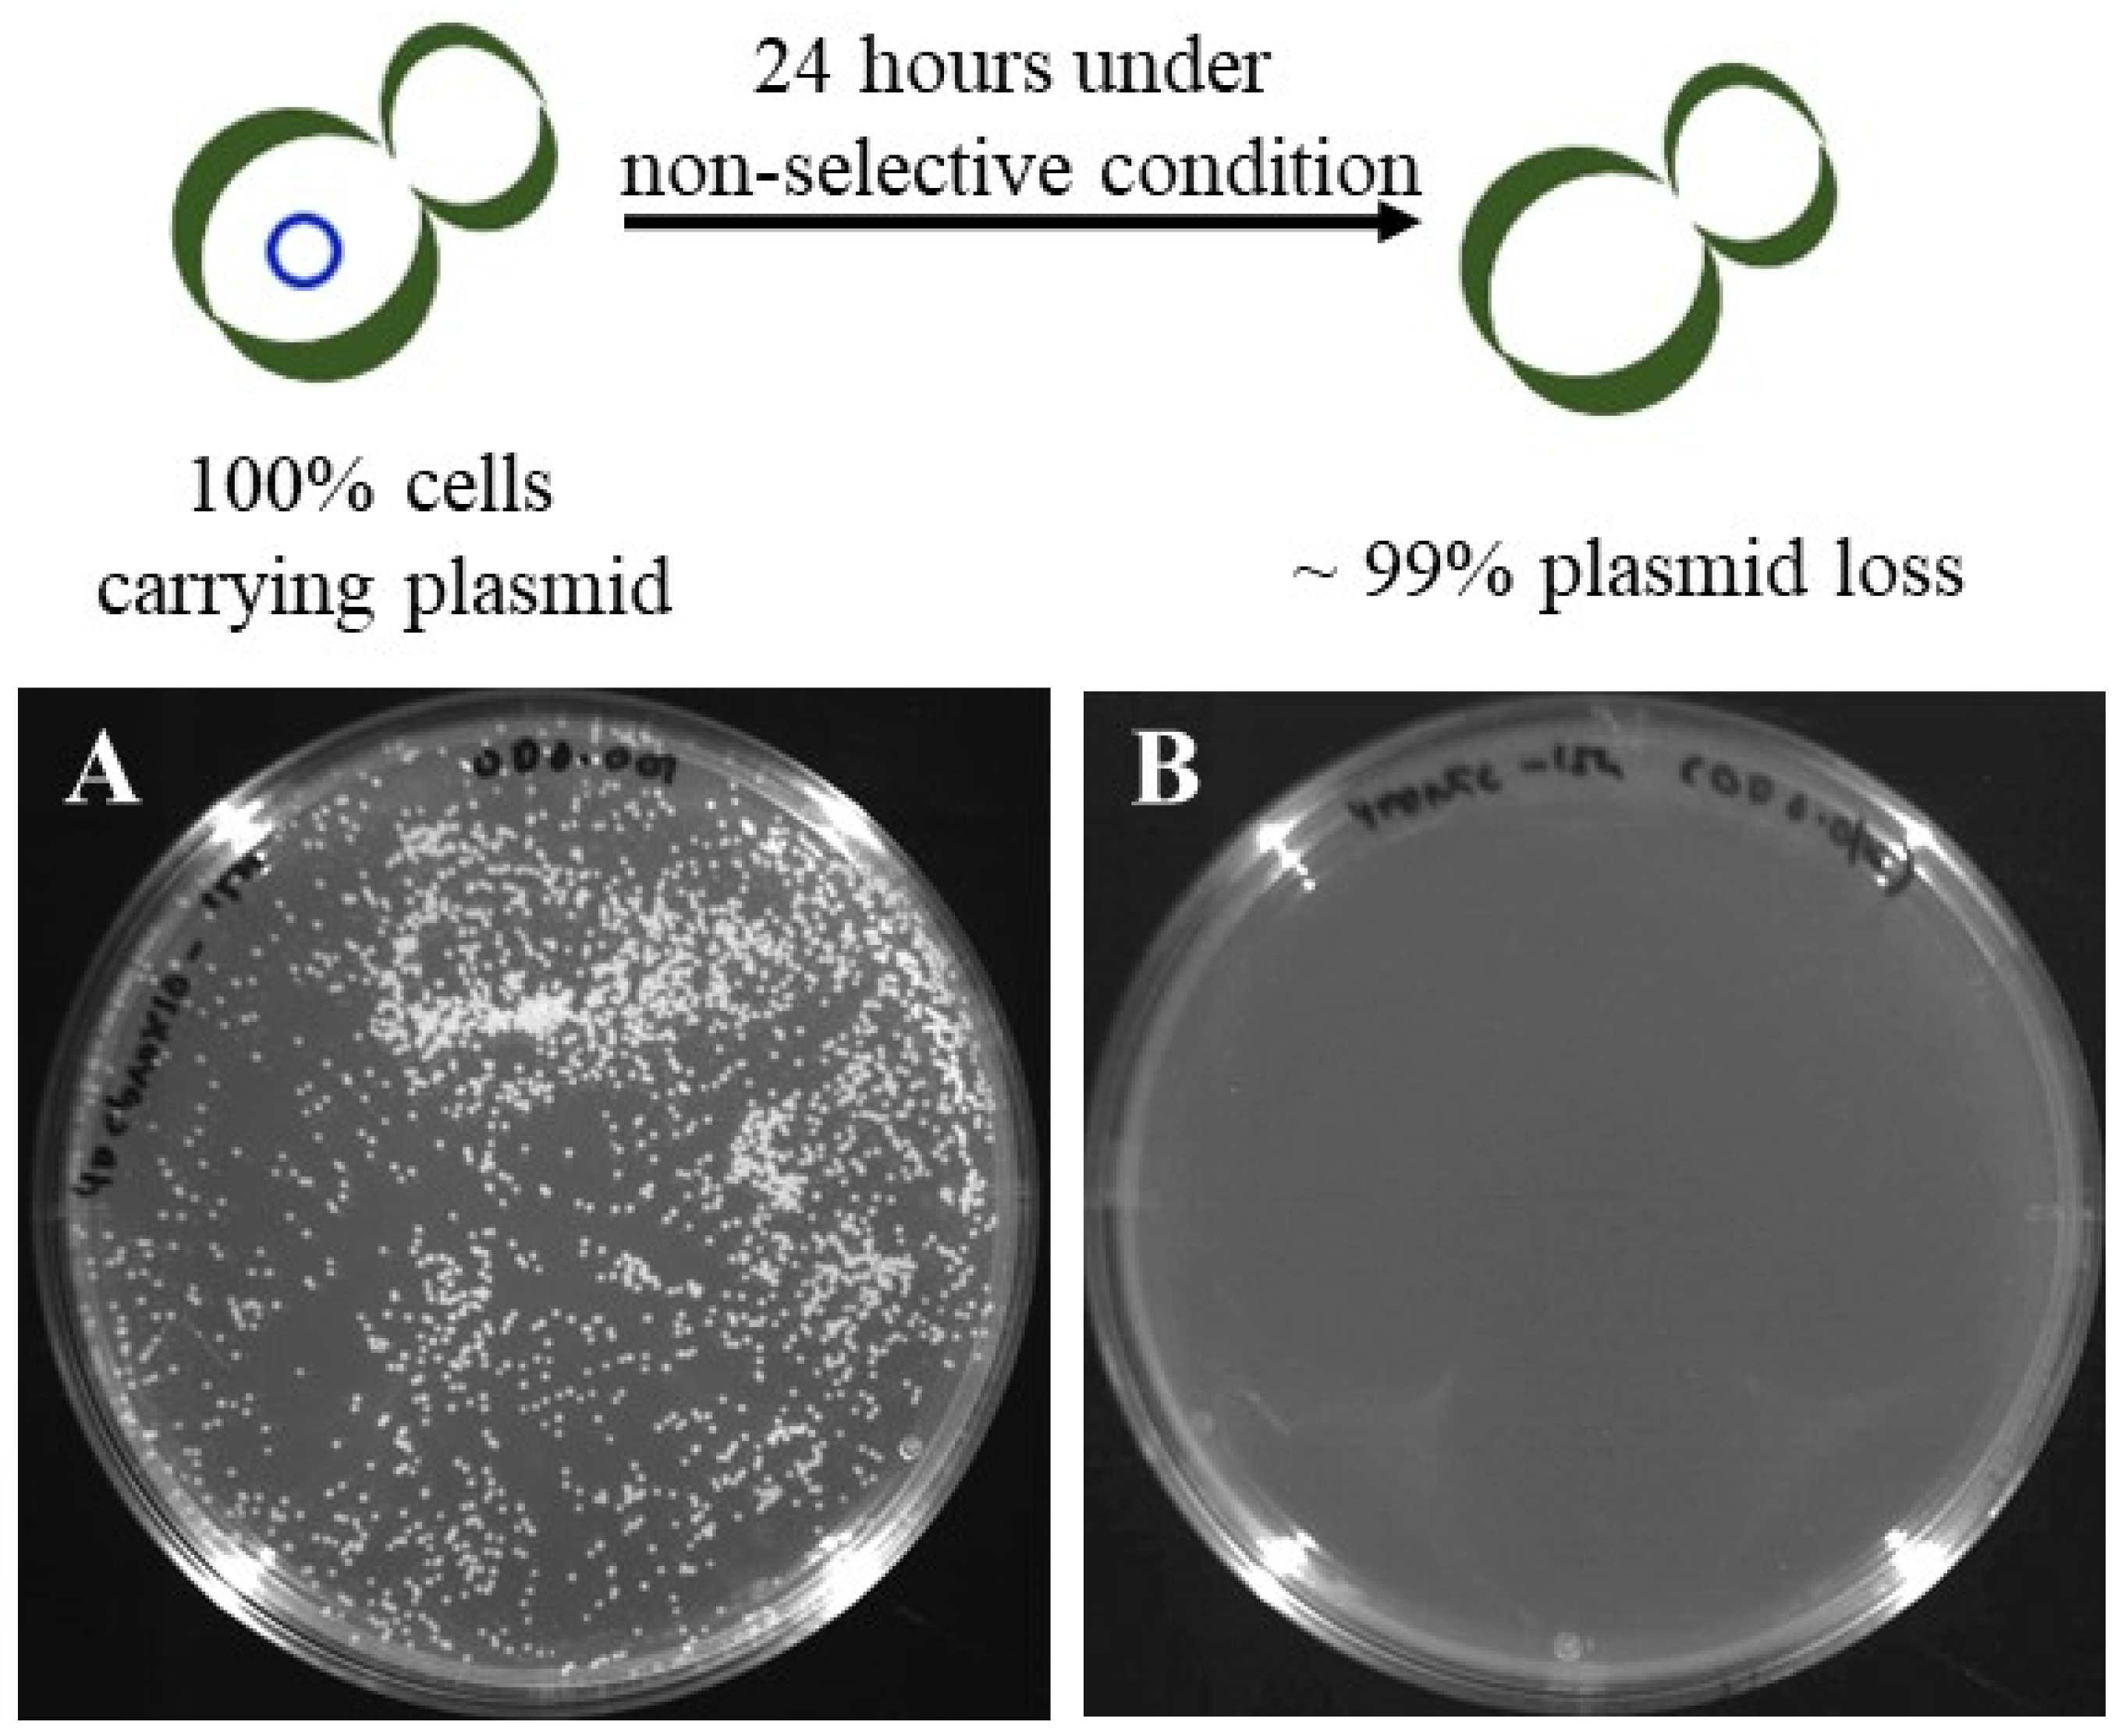
Microorganisms 08 00526 g006

Genetic Manipulation of a Lipolytic Yeast Candida aaseri SH14 Using CRISPR-Cas9 System
Abstract
1. Introduction
2. Materials and Methods
2.1. Strain, Chemicals and Media
2.2. Cloning of ARS Element and Construction of Episomal CRISPR-Cas9 Vector
2.3. Transformation and Characterization of Transformants
2.4. Screening of Recombinant C. aaseri SH14 Overexpressing CaLIP2
2.5. Analysis of dodecanedioic Acid (DDDA)
3. Results
3.1. Development of Transformation System for C. aaseri SH14
3.2. Development of CRISPR-Cas9 Expression System for C. aaseri SH14
3.3. Deletion of Multiple Genes by a Single Guide RNA
3.4. Cas9 Mediated Targeted Integration and Curing of pAN-Cas9gRNA Vector
4. Discussion
Supplementary Materials
Author Contributions
Funding
Conflicts of Interest
References
- Kim, H.; Yoo, S.J.; Kang, H.A. Yeast synthetic biology for the production of recombinant therapeutic proteins. FEMS Yeast Res. 2015, 15, 1–16. [Google Scholar] [CrossRef]
- Darvishi, F.; Fathi, Z.; Ariana, M.; Moradi, H. Yarrowia lipolytica as a workhorse for biofuel production. Biochem. Eng. J. 2017, 127, 87–96. [Google Scholar] [CrossRef]
- Nielsen, J.; Larsson, C.; van Maris, A.; Pronk, J. Metabolic engineering of yeast for production of fuels and chemicals. Curr. Opin. Biotechnol. 2013, 24, 398–404. [Google Scholar] [CrossRef]
- Deng, Y.; Ma, L.; Mao, Y. Biological production of adipic acid from renewable substrates: Current and future methods. Biochem. Eng. J. 2016, 105, 16–26. [Google Scholar] [CrossRef]
- Bart, J.C.J.; Cavallaro, S. Transiting from Adipic acid to bioadipic acid. 1, petroleum-based processes. Ind. Eng. Chem. Res. 2015, 54, 1–46. [Google Scholar] [CrossRef]
- Polen, T.; Spelberg, M.; Bott, M. Toward biotechnological production of adipic acid and precursors from biorenewables. J. Biotechnol. 2013, 167, 75–84. [Google Scholar] [CrossRef]
- Zhao, M.; Huang, D.; Zhang, X.; Koffas, M.A.; Zhou, J.; Deng, Y. Metabolic engineering of Escherichia coli for producing adipic acid through the reverse adipate-degradation pathway. Metab. Eng. 2018, 47, 254–262. [Google Scholar] [CrossRef]
- Sun, J.; Raza, M.; Sun, X.; Yuan, Q. Biosynthesis of adipic acid via microaerobic hydrogenation of cis,cis-muconic acid by oxygen-sensitive enoate reductase. J. Biotechnol. 2018, 280, 49–54. [Google Scholar] [CrossRef]
- Picataggio, S.; Rohrer, T.; Deanda, K.; Lanning, D.; Reynolds, R.; Mielenz, J.; Eirich, L.D. Metabolic engineering of Candida tropicalis for the production of long-chain dicarboxylic acids. Nat. Biotechnol. 1992, 10, 894–898. [Google Scholar] [CrossRef]
- Karlsson, E.; Mapelli, V.; Olsson, L. Adipic acid tolerance screening for potential adipic acid production hosts. Microb. Cell Fact. 2017, 16, 20. [Google Scholar] [CrossRef]
- Tsuge, Y.; Kawaguchi, H.; Sasaki, K.; Kondo, A. Engineering cell factories for producing building block chemicals for bio-polymer synthesis. Microb. Cell Fact. 2016, 15, 19. [Google Scholar] [CrossRef] [PubMed]
- Lee, S.H.; Jeong, H.; Ko, H.J.; Bae, J.H.; Ibrahim, Z.H.; Sung, B.H.; Sohn, J.H. Draft Genome Sequence of a Lipolytic Yeast. Candida aaseri SH-14. Genome Announc. 2018, 5, e00373-17. [Google Scholar] [CrossRef] [PubMed]
- Nakase, T. Four new yeast found in Japan. J. Gen. Appl. Microbiol. 1971, 17, 469–478. [Google Scholar] [CrossRef][Green Version]
- Pfüller, R.; Gräser, Y.; Erhard, M.; Groenewald, M. A novel flucytosine-resistant yeast species, Candida pseudoaaseri, causes disease in a cancer patient. J. Clin. Microbiol. 2011, 49, 4195–4202. [Google Scholar] [CrossRef] [PubMed]
- Ribeiro, O.; Gombert, A.K.; Teixeira, J.A.; Domingues, L. Application of the Cre-loxP system for multiple gene disruption in the yeast Kluyveromyces marxianus. J. Biotechnol. 2007, 131, 20–26. [Google Scholar] [CrossRef]
- Staab, J.F.; Sundstrom, P. URA3 as a selectable marker for disruption and virulence assessment of Candida albicans genes. Trends Microbiol. 2003, 11, 69–73. [Google Scholar] [CrossRef]
- Jinek, M.; Chylinski, K.; Fonfara, I.; Hauer, M.; Doudna, J.A.; Charpentier, E. A Programmable Dual-RNA–Guided DNA Endonuclease in Adaptive Bacterial Immunity. Science 2012, 337, 816–822. [Google Scholar] [CrossRef]
- Hsu, P.D.; Lander, E.S.; Zhang, F. Development and applications of CRISPR-Cas9 for genome engineering. Cell 2014, 157, 1262–1278. [Google Scholar] [CrossRef]
- Stovicek, V.; Borodina, I.; Forster, J. CRISPR-Cas system enables fast and simple genome editing of industrial Saccharomyces cerevisiae strains. Metab. Eng. Commun. 2015, 2, 13–22. [Google Scholar] [CrossRef]
- Jakočiunas, T.; Jensen, M.K.; Keasling, J.D. CRISPR/Cas9 advances engineering of microbial cell factories. Metab. Eng. 2016, 34, 44–59. [Google Scholar] [CrossRef]
- Xie, K.; Yang, Y. RNA-Guided genome editing in plants using a CRISPR-Cas system. Mol. Plant 2013, 6, 1975–1983. [Google Scholar] [CrossRef]
- Rahdar, M.; McMahon, M.A.; Prakash, T.P.; Swayze, E.E.; Bennett, C.F.; Cleveland, D.W. Synthetic CRISPR RNA-Cas9–guided genome editing in human cells. Proc. Natl. Acad. Sci. USA 2015, 112, E7110–E7117. [Google Scholar] [CrossRef]
- Wang, L.; Deng, A.; Zhang, Y.; Liu, S.; Liang, Y.; Bai, H.; Cui, D.; Qiu, Q.; Shang, X.; Yang, Z.; et al. Efficient CRISPR-Cas9 mediated multiplex genome editing in yeasts. Biotechnol. Biofuels 2018, 11, 1–16. [Google Scholar] [CrossRef]
- Jiang, F.; Doudna, J.A. CRISPR–Cas9 Structures and Mechanisms. Annu. Rev. Biophys. 2017, 505–531. [Google Scholar] [CrossRef]
- Weninger, A.; Hatzl, A.M.; Schmid, C.; Vogl, T.; Glieder, A. Combinatorial optimization of CRISPR/Cas9 expression enables precision genome engineering in the methylotrophic yeast Pichia pastoris. J. Biotechnol. 2016, 235, 139–149. [Google Scholar] [CrossRef]
- Horwitz, A.A.; Walter, J.M.; Schubert, M.G.; Kung, S.H.; Hawkins, K.; Platt, D.M.; Hernday, A.D.; Mahatdejkul-Meadows, T.; Szeto, W.; Chandran, S.S.; et al. Efficient Multiplexed Integration of Synergistic Alleles and Metabolic Pathways in Yeasts via CRISPR-Cas. Cell Syst. 2015, 1, 88–96. [Google Scholar] [CrossRef]
- Vyas, V.K.; Barrasa, M.I.; Fink, G.R. A Candida albicans CRISPR system permits genetic engineering of essential genes and gene families. Sci. Adv. 2015, 1, e1500248. [Google Scholar] [CrossRef]
- Lombardi, L.; Turner, S.A.; Zhao, F.; Butler, G. Gene editing in clinical isolates of Candida parapsilosis using CRISPR/Cas9. Sci. Rep. 2017, 7, 1–11. [Google Scholar] [CrossRef]
- Enkler, L.; Richer, D.; Marchand, A.L.; Ferrandon, D.; Jossinet, F. Genome engineering in the yeast pathogen Candida glabrata using the CRISPR-Cas9 system. Sci. Rep. 2016, 6, 35766. [Google Scholar] [CrossRef]
- DiCarlo, J.E.; Norville, J.E.; Mali, P.; Rios, X.; Aach, J.; Church, G.M. Genome engineering in Saccharomyces cerevisiae using CRISPR-Cas systems. Nucleic Acids Res. 2013, 41, 4336–4343. [Google Scholar] [CrossRef]
- Kondo, K.; Saito, T.; Kajiwara, S.; Takagi, M.; Misawa, N. A transformation system for the yeast Candida utilis: Use of a modified endogenous ribosomal protein gene as a drug-resistant marker and ribosomal DNA as an integration target for vector DNA. J. Bacteriol. 1995, 177, 7171–7177. [Google Scholar] [CrossRef]
- Gupta, N.; Rathi, P.; Gupta, R. Simplified para-nitrophenyl palmitate assay for lipases and esterases. Analytical Biochem. 2002, 311, 98–99. [Google Scholar] [CrossRef]
- Funk, I.; Rimmel, N.; Schorsch, C.; Sieber, V.; Schmid, J. Production of dodecanedioic acid via biotransformation of low cost plant-oil derivatives using Candida tropicalis. J. Ind. Microbiol. Biotechnol. 2017, 44, 1491–1502. [Google Scholar] [CrossRef]
- Cao, Z.; Gao, H.; Liu, M.; Jiao, P. Engineering the acetyl-CoA transportation system of Candida tropicalis enhances the production of dicarboxylic acid. Biotechnol. J. 2006, 1, 68–74. [Google Scholar] [CrossRef]
- Lee, H.; Han, C.; Lee, H.W.; Park, G.; Jeon, W.; Ahn, J.; Lee, H. Development of a promising microbial platform for the production of dicarboxylic acids from biorenewable resources. Biotechnol. Biofuels 2018, 11, 310. [Google Scholar] [CrossRef]
- Cao, W.; Li, H.; Luo, J.; Yin, J.; Wan, Y. High-level productivity of α,ω-dodecanedioic acid with a newly isolated Candida viswanathii strain. J. Ind. Microbiol. Biotechnol. 2017, 44, 1191–1202. [Google Scholar] [CrossRef]
- Schwartz, C.M.; Hussain, M.S.; Blenner, M.; Wheeldon, I. Synthetic RNA Polymerase III Promoters Facilitate High-Efficiency CRISPR-Cas9-Mediated Genome Editing in Yarrowia lipolytica. ACS Synth. Biol. 2016, 5, 356–359. [Google Scholar] [CrossRef]
- Ryan, O.W.; Skerker, J.M.; Maurer, M.J.; Li, X.; Tsai, J.C.; Poddar, S.; Lee, M.E.; DeLoache, W.; Dueber, J.E.; Arkin, A.P.; et al. Selection of chromosomal DNA libraries using a multiplex CRISPR system. Elife 2014, 3, e03703. [Google Scholar] [CrossRef]
- Mans, R.; van Rossum, H.M.; Wijsman, M.; Backx, A.; Kuijpers, N.G.; van den Broek, M.; Daran-Lapujade, P.; Pronk, J.T.; van Maris, A.J.; Daran, J.M.G. CRISPR/Cas9: A molecular Swiss army knife for simultaneous introduction of multiple genetic modifications in Saccharomyces cerevisiae. FEMS Yeast Res. 2015, 15, fov004. [Google Scholar] [CrossRef]
- Arras, S.D.; Chua, S.M.; Wizrah, M.S.; Faint, J.A.; Yap, A.S.; Fraser, J.A. Targeted genome editing via CRISPR in the pathogen cryptococcus neoformans. PLoS ONE 2016, 11, e0164322. [Google Scholar] [CrossRef]
- Kieliszek, M.; Kot, A.M.; Bzducha-Wróbel, A.; BŁażejak, S.; Gientka, I.; Kurcz, A. Biotechnological use of Candida yeasts in the food industry: A review. Fungal. Biol. Rev. 2017, 31, 185–198. [Google Scholar] [CrossRef]
- Pfaller, M.A.; Castanheira, M.; Messer, S.A.; Moet, G.J.; Jones, R.N. Variation in Candida spp. distribution and antifungal resistance rates among bloodstream infection isolates by patient age: Report from the SENTRY Antimicrobial Surveillance Program (2008–2009). Diagn. Microbiol. Infect. Dis. 2010, 68, 278–283. [Google Scholar] [CrossRef] [PubMed]
- Wang, H.J.; Le Dall, M.T.; Wach, Y.; Laroche, C.; Belin, J.M.; Gaillardin, C.; Nicaud, J.M. Evaluation of acyl coenzyme A oxidase (Aox) isozyme function in the n-alkane-assimilating yeast Yarrowia lipolytica. J. Bacteriol. 1999, 181, 5140–5148. [Google Scholar] [CrossRef] [PubMed]
- Fu, Y.; Foden, J.A.; Khayter, C.; Maeder, M.L.; Reyon, D.; Joung, J.K.; Sander, J.D. High-frequency off-target mutagenesis induced by CRISPR-Cas nucleases in human cells. Nat. Biotechnol. 2013, 31, 822–826. [Google Scholar] [CrossRef] [PubMed]
- Hsu, P.D.; Scott, D.A.; Weinstein, J.A.; Ran, F.A.; Konermann, S.; Agarwala, V.; Li, Y.; Fine, E.J.; Wu, X.; Shalem, O.; et al. DNA targeting specificity of RNA-guided Cas9 nucleases. Nat. Biotechnol. 2013, 31, 827–832. [Google Scholar] [CrossRef] [PubMed]

© 2020 by the authors. Licensee MDPI, Basel, Switzerland. This article is an open access article distributed under the terms and conditions of the Creative Commons Attribution (CC BY) license (http://creativecommons.org/licenses/by/4.0/).
Share and Cite
Hilmi Ibrahim, Z.; Bae, J.-H.; Lee, S.-H.; Sung, B.H.; Ab Rashid, A.H.; Sohn, J.-H. Genetic Manipulation of a Lipolytic Yeast Candida aaseri SH14 Using CRISPR-Cas9 System. Microorganisms 2020, 8, 526. https://doi.org/10.3390/microorganisms8040526
Hilmi Ibrahim Z, Bae J-H, Lee S-H, Sung BH, Ab Rashid AH, Sohn J-H. Genetic Manipulation of a Lipolytic Yeast Candida aaseri SH14 Using CRISPR-Cas9 System. Microorganisms. 2020; 8(4):526. https://doi.org/10.3390/microorganisms8040526
Chicago/Turabian StyleHilmi Ibrahim, Zool, Jung-Hoon Bae, Sun-Hee Lee, Bong Hyun Sung, Ahmad Hazri Ab Rashid, and Jung-Hoon Sohn. 2020. "Genetic Manipulation of a Lipolytic Yeast Candida aaseri SH14 Using CRISPR-Cas9 System" Microorganisms 8, no. 4: 526. https://doi.org/10.3390/microorganisms8040526
APA StyleHilmi Ibrahim, Z., Bae, J.-H., Lee, S.-H., Sung, B. H., Ab Rashid, A. H., & Sohn, J.-H. (2020). Genetic Manipulation of a Lipolytic Yeast Candida aaseri SH14 Using CRISPR-Cas9 System. Microorganisms, 8(4), 526. https://doi.org/10.3390/microorganisms8040526



